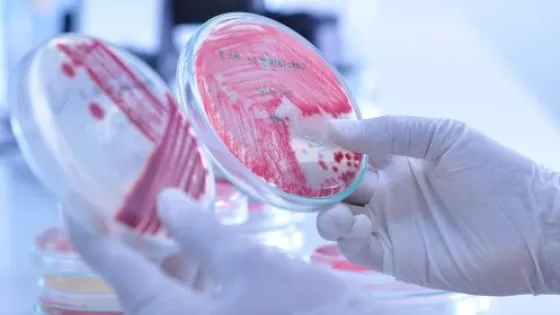
3w7s-large-v1

- Древние произведения искусства требуют бережного хранения из-за риска разрушения плесенью.
- Ученые разработали новый антисептик для защиты картин от биоповреждений.
- Антисептик протестирован на микроорганизмах-деструкторах из Третьяковской галереи.
- Плесневые грибы являются главной угрозой для объектов культурного наследия.
- Новый состав для защиты картин основан на аналогах природных аминокислот.
- Фосфоаналоги аминокислот успешно подавляют рост плесневых грибов.
- Новый антисептик не повреждает покрытие и не изменяет спектральные характеристики выкрасок осетрового клея.
- Разработка нового соединения является критически важной для расширения палитры доступных антисептиков.
«В особенной опасности находятся древние картины и иконы, написанные темперой. Такая краска на основе яичных желтков, рыбьего клея и других органических ингредиентов — отличная питательная среда для плесневых грибов и других микроорганизмов. Однако большинство антисептиков, изначально разработанных для сельского хозяйства или медицины, зачастую не пригодны для защиты произведений искусства, поскольку могут нанести вред самим картинам или быть токсичными для посетителей и реставраторов. Мы разработали и испытали более безопасные вещества – аналоги природных аминокислот», — рассказал ведущий автор работы Александр Жгун, руководитель группы генетической инженерии грибов ФИЦ Биотехнологии РАН.
«В нашей статье впервые показано, что фосфоаналоги природных аминокислот могут быть успешно использованы для защиты произведений живописи от биоповреждений. Полученные нами соединения водорастворимы, что расширяет возможности их практического применения и отличает их от многих традиционных антисептиков», — отметил Алексей Хомутов